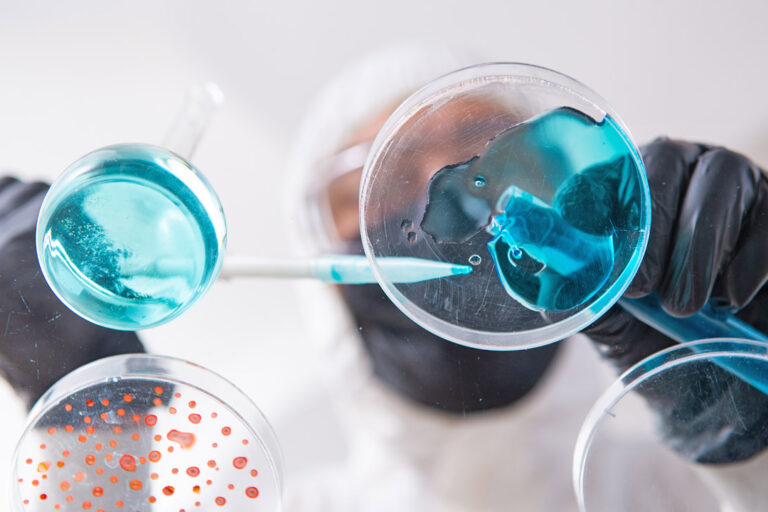

-

Mastering frozen colloid science
-

Synercore – Decade of innovation and growth in Africa’s food industry
-

What is driving growth in functional carbonated soft drinks?
-

Demystifying South African meat products vs regulations
-

IRS launches laboratory to serve South Africa’s food and beverage industry
-

Going beyond the matrix
-

Innovation in the wine-based beverages
-

Africa Food Show 2025
-

The fourth coffee wave and what to expect in the ready-to-drink beverage market
-

Enzymes: Baking’s natural revolution
-
Food testing: Beyond the lab
-

Synercore achieves FSSC 22000 certification again
